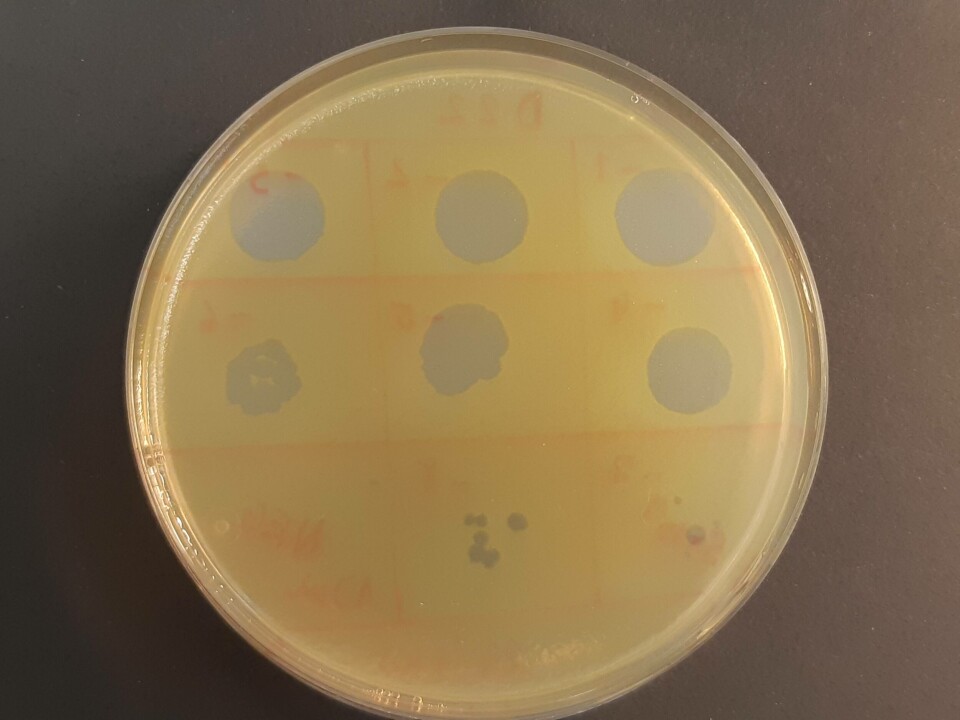

Bakterievirus kan redde laksefisk
Forskerne ved Åbo Akademi og Københavns Universitet har lykkes i å påvise at allerede lave konsentrasjoner av bakterievirus kan være effektive mot en bakterie som forårsaker bakterielle biofilmer i oppdrettsanlegg og dødelige infeksjoner hos laksefisk.
Denne artikkelen er tre år eller eldre.
De økende problemene med antibiotikaresistens hos sykdomsfremkallende bakterier i fiskeoppdrett og husdyrbruk har økt interessen for alternative biologiske bekjempingsmetoder mot ulike bakteriesykdommer. Bruk av bakterievirus, såkalte bakteriofager, som selektivt døder bakterier uten å påvirke vertsorganismen er en gammel metode som har fått en fornyet betydning i kampen mot antibiotikaresistensen.
Den tradisjonelle oppfatningen har vært at det bør være minst ti ganger høyere antall bakteriofager enn målbakterier for at fagterapien skal være effektiv, men den aktuelle studien viste at ved lokal behandling av bakterielle biofilmer og infeksjoner i fisk er bakteriofagene mer effektive enn man hadde forventet.
- Vår studie ble gjennomført med bakterien Flavobacterium psychrophilum som forårsaker sykdommen bacterial cold water disease hos laksefisk i ferskvannsanlegg og leder til betydelige økonomiske tap for oppdrettsnæringen. Våre studier har vist at bakterien mister sin sykdomsfremkallende evne i forbindelse med utvikling av fagresistens, og at det var nok bare med én bakteriofag per hundre bakterieceller for åkraftig redusere at bakteriene fester seg og danner biofilm på plastoverflater. Samtidig gikk dødeligheten hos infiserte regnbueørret signifikant ned, forteller Krister Sundell, Lotta Landor og Tom Wiklund, miljø- og marinbiologiforskere ved laboratoriet for akvatisk patobiologi ved Åbo Akademi.
Minsker risikoen
For å kunne benytte fagterapi i oppdrettsanlegg må man utvikle en praktisk metode, for eksempel å få inn bakteriofagene via fôret, noe som har vist seg å være problematisk i preliminære forsøk. Et annet viktig poeng er å forhindre at det oppstår bakteriofagresistens hos målbakteriene.
- Man kan minske risikoen for bakteriofagresistens for eksempel ved å samtidig anvende flere ulike typer av bakteriofager som fester seg på ulike molekyler på bakterienes overflate når man behandler infeksjoner. Bakteriofagene er meget vertsspesifikke og angriper bare sin egen vertsbakterieart uten å ha en skadelig effekt på verken fiskens eller menneskets celler. Fordi de også isoleres fra miljøer der deres bakterieverter allerede fins, blir det ikke sluppet løs noen fremmede organismer i miljøet.
Likevel fins det forskjeller mellom ulike bakteriofager og hvor raskt og effektivt de ødelegger en bakteriecelle. For å kunne bruke et kommersielt fagprodukt på markedet kreves det både dyp og detaljert grunnforskning og dokumentasjon om fagpreparatets sikkerhet.
Studiene om fagterapiens muligheter for behandling av flavobakteriose i oppdrettsanlegg er blitt utført innen det internasjonale samarbeidsprosjektet BONUS FLAVOPHAGE, som har ført sammen forskere og sakkyndige fra Finland, Danmark, Polen og Skottland.
Resultatene av undersøkelsen Bacteriophages as biocontrol agents for Flavobacterium psychrophilum biofilms and rainbow trout infections er blitt publisert i det vitenskapelige tidsskriftet PHAGE: Therapy, Applications, and Research.